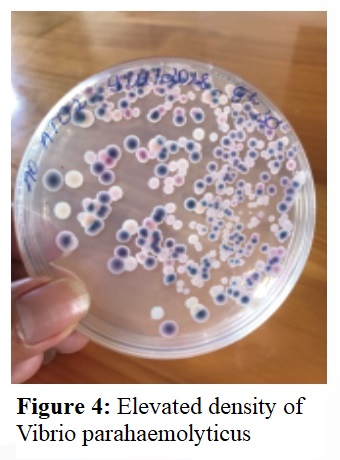

- Address: Lot No. 20, Zone G, D1 Street, An Ha Industrial Park, Tan Vinh Loc Commune, Ho Chi Minh City
- Phone: (84-28) 668.36156 / 668.36158
- Hotline: 1800.9435
- Fax: (84-28) 3620.4694
- Email: vibo@vibo.com.vn
- Website https://vibo.com.vn/

Acute Hepatopancreatic Necrosis Disease (AHPND), also known as Early Mortality Syndrome (EMS), is a major disease in shrimp aquaculture.
The syndrome is closely associated with poor pond management, with Vibrio parahaemolyticus being the primary pathogenic agent (Figure 1).

• Stage 1 (Shrimp < 30 days old):
Mortality at this stage may stem from poor-quality postlarvae already infected at the hatchery, inadequate pond preparation, or transmission from intermediate hosts.
(Figures 2 & 3: Black tiger shrimp and whiteleg shrimp with early-stage hepatopancreatic disease)
• Stage 2 (Shrimp 31–60 days old):
Mortality during this period results mainly from poor pond management—overfeeding, accumulation of organic waste, and deteriorating pond-bottom conditions—leading to elevated harmful Vibrio density.

Clinical signs of hepatopancreatic disease can be categorized according to the progression stage:
Shrimp show no increase in feed intake; water tests reveal rising levels of Vibrio parahaemolyticus (>5×10² CFU/mL).
(Figure 4: Elevated Vibrio parahaemolyticus density)
Shrimp reduce feed intake by 10–15%, with signs of reduced gut content, hepatopancreas swelling, and yellow discoloration.
(Figure 5: Shrimp with swollen hepatopancreas)

Feed intake drops by 15–20%; hepatopancreas begins to shrink; shrimp show empty gut and sporadic mortality.
(Figure 6: Shrimp with shrunken hepatopancreas and empty gut)

Feed reduction may reach 50%; hepatopancreas is severely shrunken and pale; many shrimp are empty-gutted, resulting in significantly higher mortality in feeding trays.
(Figure 7: Shrimp showing sharp decline in tray sampling)

Routine broad-spectrum disinfection: Apply AQUA CIDE once per week.
48 hours after disinfection, apply PROCA 2x to stabilize the microbiome and suppress pathogenic Vibrio.
Add organic waste–degrading probiotics (VB-EM super) twice per week to reduce toxic gases and organic load.

Supplement herbal garlic extract GATONIC PLUS + digestive enzyme VIBOZYME PLUS to boost natural immunity.
Enhance digestion and hepatopancreas function using BACITAL + LIVERMIN PLUS.
During sudden weather changes (heavy rain, intense sunlight), apply 1 L YUCCA-S PLUS / 1,000–1,500 m³ to reduce stress and stabilize water quality.
Apply VB-ANTIDOX to reduce turbidity and heavy metals and improve the effectiveness of disinfection.
Perform targeted disinfection using WIN 500 new. After 2 days, apply PROCA 2x to suppress pathogenic Vibrio.
Reduce feed by 30–50% and mix VB-RIDO 01 + GATONIC PLUS into the feed.

Withhold feed and apply YUCCA-S PLUS to reduce stress before disinfecting with WIN 500 new.
Treat infected shrimp by mixing VB-RIDO 01 + ZX 2000 + VIBOZYME PLUS into the feed.

Vibo Technical Department
